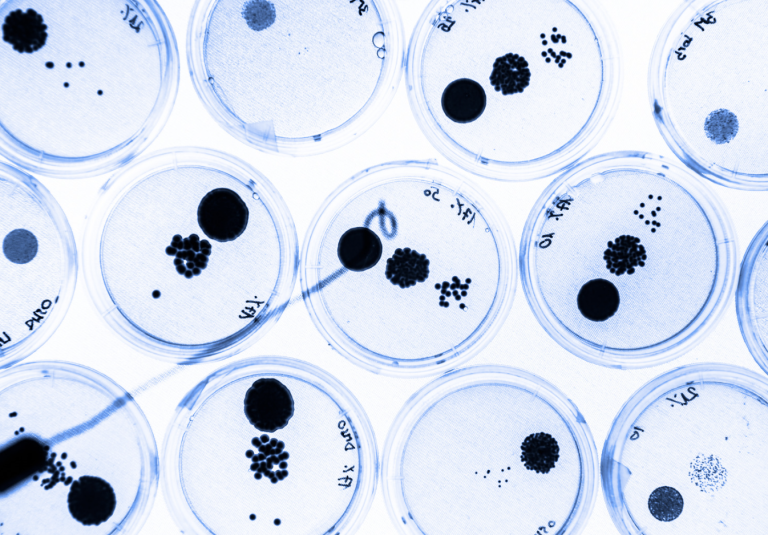
How to favour access to new antimicrobials

The European Commission has published the EU Innovation Scoreboard 2024 (EIS), the annual report that since 2001 takes stock of the research and innovation (R&I) activities in the different member countries, as well as some neighbouring countries and third countries of particular competitive significance.
The EIS data can also be browsed online at this link; the interactive tool allows for a comparison of scores for specific areas of interest and allows for viewing individual country profiles, including an assessment of strengths and weaknesses and trends.
Also for this edition of the EIS, the measurement framework introduced in 2021 and comprising 32 indicators was applied. The data analysed refer to the five-year period 2017-2024. A subset of 19 indicators was used to compare the EU’s performance with that of eleven global competitors.
The main results for 2024
The overall figure emerging from the European Innovation Scoreboard 2024 shows that overall innovation performance has improved by an average of 10 per cent over the last five years. At the level of individual member states, this trend is in many cases confirmed, albeit at different levels for individual countries (with the sole exception of Luxembourg). The most significant improvements were recorded by Cyprus and Estonia (+39% and +27%, respectively); a large group of countries, on the other hand, grew by less than 5% over the 2017-2024 period (Romania, France, Ireland, Slovakia, Latvia, Bulgaria, Germany, Portugal, Austria, Slovenia).
More specifically, the last year considered (2023-2024) saw an average increase in innovation performance of 0.6% (in line with the previous year), with 15 countries showing a growth trend (> 3% for Lithuania, Poland and Cyprus), while 11 others saw a decline in their performance. Only Croatia remained stable.
The 2024 edition of the report also divided the EU countries into four different innovation groups, based on their scores. The Innovation Leaders comprise the countries with a performance greater than 125% of the EU average (Denmark, Sweden, Finland and the Netherlands). Strong Innovator countries include Belgium, Austria, Ireland, Luxembourg, Germany, Cyprus, Estonia and France (performance between 100% and 125% of the EU average). Italy ranks among the Moderate Innovator countries, together with Slovenia, Spain, Czech Republic, Malta, Lithuania, Portugal, Greece and Hungary (70%-100% of the EU average). Emerging Innovators, finally, have innovation rates below 70% of the average and include Croatia, Poland, Slovakia, Latvia, Bulgaria and Romania.
Among the non-EU neighbouring countries, Switzerland was found to be the most innovative country, due to its attractive research systems, human resources and intellectual property management, and business investment. Globally, South Korea emerged as the most innovative competitor, with a performance exceeding the EU average of 21.1%. Canada, the United States and Australia also outperform the EU, as they did in 2023; finally, China has increased its innovation rate by 28.2% since 2017, catching up with Japan and moving closer to the EU.